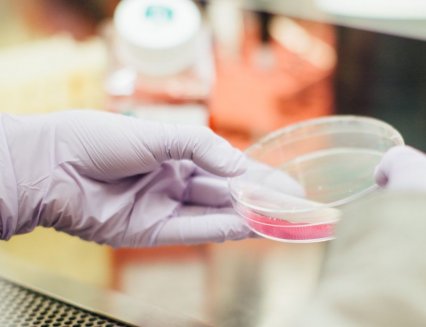

Новости по тегу
вирус Эбола
На территории небольшой африканской страны Уганда продолжаются случаи заражения вирусом Эбола. Количество смертей уже достигло 10 человек, и среди них медицинские работники. Ещё один медик скончался от последствий лихорадки Эбола на территории Уганды, так что число смертей теперь достигло 10 человек. Местные санитарные органы изо всех сил...
Похожий на лихорадку Эбола вирус, живущий в организме африканских обезьян, уже готов перепрыгнуть на людей. Исследование американских ученых показывает, что он способен спровоцировать следующую по счёту пандемию. Ученые опасаются, что выявили новую угрозу будущей пандемии - вирус, который живёт в организме африканских обезьян. Речь о вирусе...
Вирус Эбола начал распространение по Уганде впервые со времён коронавирусной пандемии. Сообщается о смерти 24-летнего мужчины, который заразился коварным патогеном. Из-за распространения по миру COVID-19 человечество несколько подзабыло о существовании гораздо более коварного патогена вируса Эбола. И напрасно, так как он убивает до 50% своих...
В Демократической Республике Конго зафиксирована вторая по счёту смерть в ходе свежей вспышки вируса Эбола. Местные специалисты в области здравоохранения признаются, что сейчас время не на их стороне. Вирус Эбола спровоцировал уже вторую смерть в Демократической Республике Конго в ходе свежей по времени вспышки. Местные санитарные органы пытаются...
Исследователи из США выяснили, что вирус Эбола способен надолго скрыться в мозге и впоследствии вызвать рецидив даже после лечения. А этот патоген, как известно, нередко приводит своих носителей к смерти. Учёные из Медицинского научно-исследовательского института инфекционных болезней при армии США обнаружили, что около 20% обезьян, переживших...
Не менее 5 жителей Гвинеи скончались от заражения вирусом Эбола. Это первая вспышка болезни с тех пор, как 5 лет тому назад ее жертвами стали 11 300 жителей Западной Африки. Как стало известно, в Гвинее 5 человек скончались от заражения вирусом Эбола, и местные команды по чрезвычайным ситуациям уже начали реагировать на эту вспышку. Речь может...
Эбола и Марбург являются одними из самых смертоносных вирусов, уровень смертности от этих инфекций составляет от 25% до 90%. Хотя в настоящее время на рынке нет лекарств для предотвращения заражения этими вирусами - они относятся к категории вирусов, называемых филовирусами, которые, как известно, вызывают геморрагическую лихорадку. Исследователи...
Новая вакцина оказалась высоко защищающей от смертельной инфекции вируса Эбола у мышей после одной инъекции. Хотя мир сосредоточен на поиске вакцины против коронавируса COVID-19, исследования продолжаются в отношении других потенциально пандемических заболеваний, включая вирусы Эбола и Марбург. Мир не может позволить себе игнорировать другие...
Житель Конго стал первым в истории страны пациентом, который вновь заразился вирусом Эбола после выздоровления. А это рождает опасения новой вспышки вируса в данной африканской стране через несколько недель после победы над ней. В Демократической Республики Конго обнаружен пациент с вирусом Эбола, который однажды уже переболел этой опасной...
Почти 5 000 человек скончались в этом году от худшей в истории вспышки кори в Демократической Республике Конго. Отметим, что эта страна и без того страдает от эпидемии вируса Эбола. Корь убила почти 5 000 человек в Демократической Республике Конго в этом году, как заявили власти. В 2019 году жертвами этой болезни стали около четверти миллиона...
Европейские регуляторы дали добро на использование первой в истории вакцины против вируса Эбола. Это произошло после того, как препарат оказался успешным в Демократической Республике Конго. Главное регулирующее здравоохранение европейское ведомство одобрила вакцину от лихорадки Эбола, и данный шаг некоторые эксперты уже называют триумфом...
Местного пациента срочно доставили в больницу со всеми классическими симптомами опаснейшей болезни. Врачи утверждают, что точный диагноз будет поставлен только после завершения всех стадий диагностики. Опаснейшая африканская болезнь вирус Эбола могла добраться до благополучной Швеции. Местные медики расследуют случай заболевания одного из...
Пять лет назад в Западной Африке разразилась вспышка Эболы, в результате которой погибло более 11 000 человек. Во время вспышки 2014 года не было доступных эффективных вакцин или методов лечения, в то время как ответ международного сообщества часто воспринимался как слишком реактивный. Об этом пишет JapanTimes. В 2018 году Эбола снова нанесла...
Вирус эболы распространяется на другие государства. Если ранее с этим вирусом боролись в Конго, то теперь очередь пришла республике Уганда. Всемирная организация здравоохранения (ВОЗ) констатировала случай заражения эболой в Уганде. Здесь вирус переместился на детей. В частности, 9-летняя девочка пыталась проникнуть в Уганду через границу...
Два новых лекарства от коварной болезни радикально повысили выживаемость пациентов. К такому выводу пришли исследователи из Всемирной организации здравоохранения. Ученые вплотную приблизились к победе над очень опасным заболеванием - вирусом Эбола. Это произошло после того, как в ходе клинических исследований два новых экспериментальных препарата...
Вспышка вируса Эбола, которая уже убила 75 жителей Демократической Республики Конго за 4 недели, может стать худшей в истории. Эксперты настоятельно призывают мировое сообщество вмешаться, пока не поздно. У новой вспышки вируса Эбола есть потенциал стать худшей в истории, как полагают представители Международного комитета помощи, работающие в...
Массовая вакцинация не остановит вспышку вируса Эбола, как предупреждают ученые. Существуют реальные опасения о том, что очень скоро эта болезнь превратится в эпидемию в Демократической Республике Конго. Массовая вакцинация не станет способом сдерживания эпидемии вируса Эбола, которая может разыграться в Демократической Республике Конго. Местные...